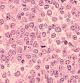
Horizontal

Josep Dalmau, profesor de investigación del Institut d’Investigacions Biomèdiques August Pi i Sunyer (IDIBAPS) y del Hospital Clínic, está emprendiendo uno de los proyectos más ambiciosos para estudiar la encefalitis autoinmune más frecuente, causada por anticuerpos contra una proteína del cerebro llamada NMDA.
“Afecta sobre todo a jóvenes y niñas, o en un 75% de casos a pacientes del sexo femenino”, explica Dalmau. La enfermedad se presenta de manera rápida con cambios de tipo psicótico que casi siempre se acompañan de problemas neurológicos como crisis epilépticas, movimientos anormales, disminución del nivel de conciencia o coma. “En esa fase, el paciente ingresa en el hospital, donde puede pasar varios meses. Al salir, queda una larga fase de recuperación, en la que seguirán padeciendo alteraciones cognitivas y de conducta durante meses o años, con importantes consecuencias en el plano social, económico y familiar”, añade el científico.
Para investigar la enfermedad, el equipo de Dalmau reclutará a pacientes de toda España para hospitalizarlos un día y medio, tres veces al año, y someterlos a una serie de pruebas no invasivas. “Les exploraremos neurológicamente, incluyendo estudios neuropsicológicos, electroencefalograma, resonancia magnética cerebral, y análisis de la función cerebral durante el sueño. Al mismo tiempo, investigaremos varios biomarcadores de inflamación del cerebro y neurodegenerativos”, detalla el investigador.
Fuera del hospital, durante un año, el equipo evaluará y monitorizará las habilidades cognitivas de los pacientes mientras hacen ejercicios, tests y pruebas con una aplicación móvil conectada a un dispositivo portátil colocado varios días en la cabeza, que analizará su actividad cerebral. También trabajará en el laboratorio con un modelo animal de la enfermedad. Con todo, los investigadores confían en que desvelarán los entresijos de cómo se desarrolla la enfermedad, cómo combatirla y superarla.
La sección Preguntas Big Vang está financiada por la Fundación La Caixa.